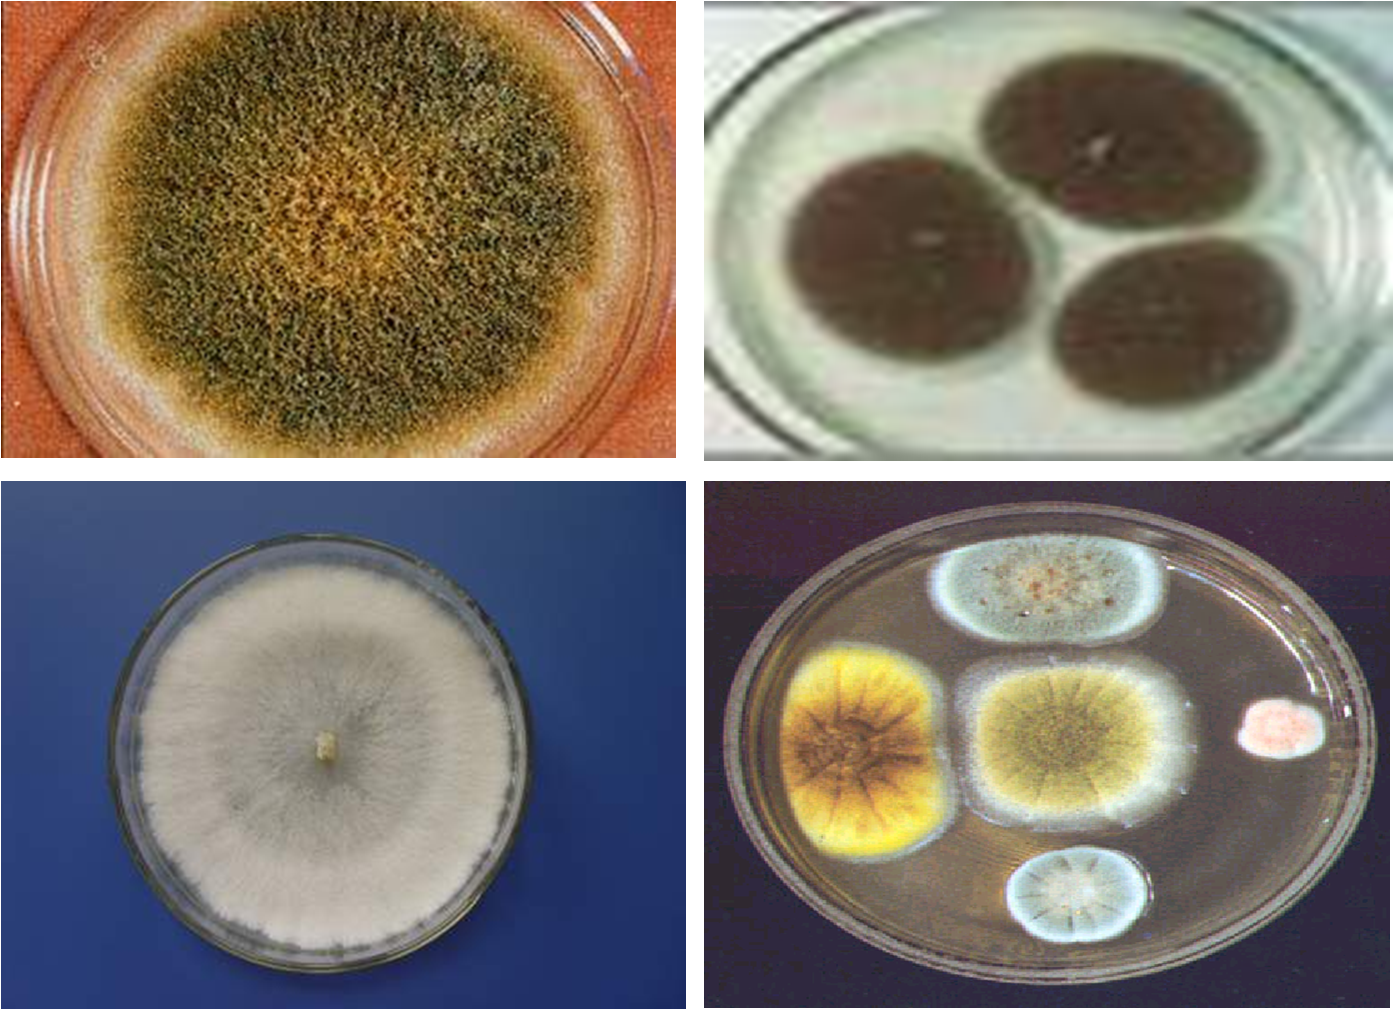

-
1 内容
-
2 练习
内容

霉菌的形态结构
菌丝

霉菌菌体均由分枝或不分枝的菌丝构成。许多菌丝交织在一起,称为菌丝体。霉菌的菌丝可分为基内菌丝、气生菌丝和孢子丝。
菌丝的特化
◆ 菌环:菌营养菌丝和气生菌丝对于不同的真菌来说,在它们的长期进化过程中,对于相应的环境条件丝交织成套状
◆ 菌网:菌丝交织成网状

◆ 附枝:匍匐菌丝、假根(类似树根,吸收营养),功能是固着和吸收营养。

◆ 子座:菌丝交织成垫状、壳状等,在子座外或内可形成繁殖器官。

霉菌的繁殖方式
◆ 无性繁殖产生厚垣孢子、节孢子、分生孢子、孢囊孢子等;
不经两性细胞配合,只是营养细胞的分裂或营养菌丝的分化(切割)而形成新个体的过程。
◆ 有性繁殖产生接合孢子、子囊孢子、担孢子等;



两个性细胞结合产生新个体的过程:
● 质配:两个性细胞结合,细胞质融合,成为双核细胞,每个核均含单倍染色体(n+n)。
● 核配:两个核融合,成为二倍体接合子核,此时核的染色体数是二倍(2n)。
● 减数分裂:具有双倍体的细胞核经过减数分裂,核中的染色体数目又恢复到单倍体状态。
霉菌的生活史
无性繁殖阶段:菌丝体(营养体)在适宜的条件下产生无性孢子,无性孢子萌发形成新的菌丝体,多次重复。
有性繁殖阶段:在发育后期,在一定条件下,在菌丝体上分化出特殊性器官(细胞),质配、核配、减数分裂后形成单倍体孢子,再萌发形成新的菌丝体。

霉菌的代表属
● 根霉属(Rhizopus)
● 毛霉属(Mucor)
● 曲霉属(Aspergillus)
● 青霉属(Penicillinm)




霉菌的菌落
固体培养:菌落形态较大,质地一般比放线菌疏松,外观干燥、不透明,呈现或紧或松的蛛网状、绒毛状或棉絮状;菌落与培养基的较紧密,较易挑取。菌体可沿培养基表面蔓延生长,由于不同的真菌孢子含有不同的色素,所以菌落可呈红、黄、绿、青绿、青灰、黑、白、灰等多种颜色。菌落正反面的颜色和边缘与中心的颜色常不一致等。
液体培养:如果是静止培养,菌丝往往在液体表面生长液面上形成菌膜。如果是震荡培养,菌丝可相互缠绕在一起形成菌丝球,亦可形成絮片状,与震荡速度有关。
案例
毛霉腐乳的制作
腐乳,又因地而异称为“豆腐乳”,是一种二次加工的豆制食品,是我国著名的具民族特色的发酵调味品,为华人的常见佐菜,或用于烹调。通常腐乳主要是由用毛霉菌发酵的,包括腐乳毛霉、鲁氏毛霉、总状毛霉等。
目前我国各地都有腐乳的生产,它们虽然由于大小不一,配料不同,品种名称繁多,但制作原理大都相同。首先将大豆制成豆腐,然后压坯划成小块,摆在木盒中即可接上蛋白酶活力很强的毛霉或根霉菌的菌种,接着便进入发酵和腌坯期。最后根据不同品种的要求加以红曲酶、酵母菌、米曲霉等进行密封贮藏。腐乳的独特风味就是在发酵贮藏过程中所形成。在这期间微生物分泌出各种酶,促使豆腐坯中的蛋白质分解成营养价值高的氨基酸和一些风味物质。有些氨基酸本身就有一定的鲜味,腐乳在发酵过程中也促使豆腐坯中的淀粉转化成酒精和有机酸,同时还有辅料中的酒及香料也参与作用,共同生成了带有香味的酯类及其他一些风味成分,从而构成了腐乳所特有的风味。腐乳在制作过程中发酵,蛋白酶和附着在菌皮上的细菌慢慢地渗入到豆腐坯的内部,逐渐将蛋白质分解,大约经过三个月至半年的时间,松酥细腻的腐乳就做好了,滋味也变得质地细腻、鲜美适口。
简易制作流程:豆腐的毛霉发酵——加盐腌制——装罐——成品
豆腐的毛霉发酵
把买回来的水豆腐按照自己要求的大小切成小块,晾干水分,放入可密封容器里(豆腐块上生长的毛霉来自空气中的毛霉孢子,而现代的腐乳生产是在严格无菌的条件下,将优良毛霉菌种直接接种在豆腐上,这样可以避免其他菌种的污染,保证产品的质量),只能放一层,因为豆腐软易压坏。将容器里的温度控制在15~18℃,并保持在一定的湿度。约48小时后,毛霉开始生长,3天之后菌丝生长旺盛,5天后豆腐块表面布满菌丝。
加盐腌制
将长满毛霉的豆腐块分层整齐地摆放在瓶中,同时逐层加盐,随着层数的加高而增高盐量,接近瓶口表面的盐要铺厚一些。加盐研制的时间约为8天左右。加盐可以析出豆腐中的水分,使豆腐块变硬,在后期的制作过程中不会过早酥烂。同时,盐能抑制微生物的生长,避免豆腐块腐败变质。
配置卤汤
卤汤直接关系到腐乳的色、香、味。卤汤是由酒及各种香辛料配制而成的。卤汤中的酒可以选用料酒、黄酒、米酒、高粱酒等,含量一般控制在12%左右。加酒可以抑制微生物的生长,同时能使腐乳具有独特的香味。香辛料种类很多,如胡椒、花椒、八角、桂皮、姜、辣椒等。香辛料可以调制腐乳的风味,也具有防腐杀菌的作用。可据个人口味配置卤汤。


